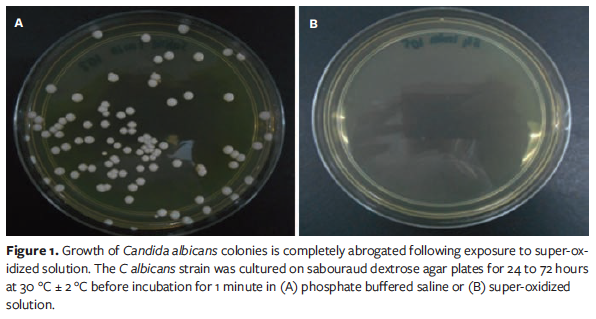
Figure 1
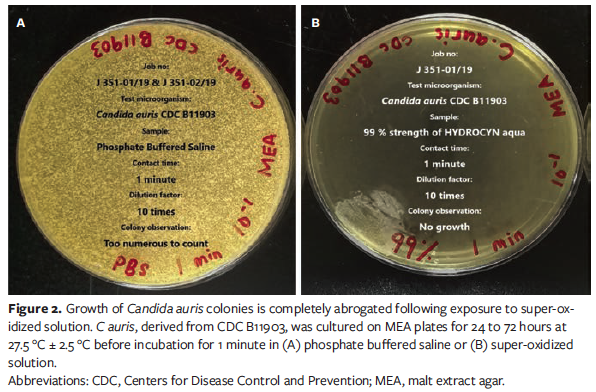
Figure 2

Fungicidal Effectiveness of Super-Oxidized Solution In Vitro: Potential Implications for Wound Care
Abstract
Introduction. Drug-resistant fungal infections in chronic wounds represent a major clinical challenge to clinicians. Fungal infections delay wound healing by prolonging inflammation and encouraging biofilm formation, which protects microbes against host defenses and anti-infective medications. As such, interventions that prevent and control nosocomial fungal infections without interfering with the wound healing process are increasingly required. Although conventional antiseptics can effectively exert fungicidal effects, they also have adverse effects on human cells. SOS is a well-known bactericidal agent that enhances the wound healing process, especially for chronic wounds. However, few studies have evaluated the antimicrobial activity of SOS on fungi. Objective. The objective of this study was to evaluate whether SOS exerts fungicidal activities against common fungal species. Materials and Methods. The efficacy of SOS was tested against 6 fungal species (Candida albicans, Candida auris, Candida tropicalis, Candida parapsilosis, Sporothrix schenckii, Trichophyton mentagrophytes) using an in vitro time-kill assay. Results. SOS achieved 99.9999% reduction of all tested fungi within 1 minute of exposure. Conclusions. This study shows that SOS may be an effective tool for the prevention and control of fungal infections.
Introduction
Chronic wounds represent a growing public health concern.1 Although the etiology of different types of chronic wounds varies, infections strongly influence the development of chronic wounds and exacerbate their nonhealing nature.1 Infections impede the wound healing process by triggering the body’s immune system to cause prolonged inflammation and further tissue damage.2 Moreover, fungal infections are a challenging complication when treating chronic wounds such as venous ulcers, pressure injuries, and diabetic foot ulcers.3,4 Although the exact prevalence of fungal infections in chronic wounds is unclear, a review published in 2023 noted that chronic wound-related fungal infections are often overlooked in clinical practice; fungal infection rates likely substantially exceed current estimates.1 Owing to variable presentations and definitions of fungal infections, as well as a lack of clinical awareness of diagnostic best practices, fungal infections are frequently misdiagnosed.5,6 Tissue cultures should ideally be used to diagnose and appropriately treat fungal infections.7 In addition, the choice of an appropriate agent depends on the infecting fungal strain and its drug susceptibility profile.8,9 Some clinicians may prefer to use more than 1 antifungal drug to treat fungal infections to ensure broad-spectrum coverage; however, overexposure to antifungals may promote the development of antifungal resistance.10 Moreover, fungi can contribute to polymicrobial biofilm development, which further protects any bacterial and fungal species in chronic wounds from antibiotics, antifungals, and host immune defenses.1
The importance of adopting alternative infection management measures, such as topical antiseptics, is increasingly recognized; however, conventional antiseptics, such as povidone-iodine, can interfere with wound healing.1 SOS, also known as electro-activated water, is an antimicrobial agent composed of purified water and pure vacuum-dried sodium chloride, which breaks down into sodium hypochlorite and HOCl when an electric current passes through the water.11,12 HOCl is a nonselective oxidant well-known for its antimicrobial properties.13,14 Moreover, unlike conventional antiseptics, available evidence suggests that SOS-derived HOCl does not adversely affect human cells.15 Furthermore, there is evidence that HOCl plays a crucial role in wound management owing to its antimicrobial and anti-inflammatory properties.16 These properties have led to the therapeutic applications of HOCl in wound healing, pruritus, diabetic ulcers, and the management of several inflammatory cutaneous disorders.16,17
Existing research highlights the role SOS plays in wound management; studies have shown that SOS inhibits the growth of pathogenic microorganisms in wounds.12,16,18-20 Interestingly, SOS has also demonstrated antimicrobial activity against antibiotic-resistant species, including methicillin-resistant Staphylococcus aureus, in vitro.20 Nevertheless, there is limited evidence on the effect of SOS on fungi. In light of a recent increase in antifungal-resistant infections,9 the authors of the current study conducted an in vitro time-kill study to evaluate whether a specific SOS (Hydrocyn Aqua; Bactiguard) demonstrated fungicidal activities against common fungal species.
Materials and Methods
Microbiological testing with time-kill procedure (ASTM E2315-16) was conducted by 2 accredited laboratories (Industrial Biotechnology Research Centre, Selangor, Malaysia; BioScience Laboratories, LLC, Montana, United States) to assess the effect of SOS against 6 fungal species: Candida albicans, Candida auris, Candida tropicalis, Candida parapsilosis, Sporothrix schenckii, and Trichophyton mentagrophytes. The basic concept of the time-kill kinetic study is to establish the rate at which a microorganism is killed by a product as a function of survival data recorded at specific exposure time points.
A measured volume of each microorganism suspension (9 mL for C albicans, C auris, S schenckii, and T mentagrophytes; 10 mL for C tropicalis and C parapsilosis) was transferred into the SOS test solution for 1 minute. Following this, 0.1 mL of each test sample was transferred to agar plates (culture medium: sabouraud dextrose agar for C albicans, malt extract agar for C auris, Emmon’s sabouraud dextrose agar for S schenckii and T mentagrophytes, and tryptic soy agar for C tropicalis and C parapsilosis) and incubated for 24 to 72 hours at 30 °C ± 2 °C for C albicans; 24 to 72 hours at 27.5 °C ± 2.5 °C for C auris, C tropicalis, and C parapsilosis; 5 to 10 days at 25 °C ± 2 °C for S schenckii; and 2 to 10 days at 25 °C ± 2 °C for T mentagrophytes. Microbial counts were recorded after incubation, and log and percent reductions were subsequently calculated using the following formulae:
Log10 reduction (LR) = mean log10 (measured initial microbial population) − mean log10 (surviving microbial population)
and
Percent reduction (%) = 100 × (1−10−LR),
respectively.
The same process was followed for the control solution, phosphate buffered saline.
In general, a 2 log10 reduction is considered the minimum level of performance to demonstrate a substantive killing activity against a particular microorganism. Any reduction value less than 2 log10 indicates that a relatively large number of microorganisms remain viable after treatment with the product. For example, a 1 log10 reduction in a population of 1 million bacteria means that 100 000 bacteria remain viable. The final microbial reduction should be greater than 2 log10, or greater than a 99% reduction, in a given exposure time for the product to be considered to have antimicrobial properties.

Results
SOS met the minimum threshold required to be considered fungicidal (2 log₁₀ reduction) against all 6 fungal species and reduced microbial counts by 99.9999% (Table 1). Log10 reduction was highest for C auris (Table 1). As seen in Figure 1 and Figure 2, respectively, C albicans and C auris colonies were nearly nonexistent after 1-minute exposure to SOS; however, there continued to be a substantial colony presence in the controls.

Discussion
These results are in line with those of previous studies indicating that SOS, and HOCl in general, has the potential to be the antimicrobial agent for wound disinfection, irrigation, and dressing.16-22 The presence of fungi in chronic wounds delays wound healing by prolonging inflammation, perduring infection, and, in certain cases, contributing to biofilm formation.1 The prevalence of fungal infections varies across different types of chronic wounds, and fungal infection rates are likely to be substantially higher than reported in clinical practice.1 Although incidence rates vary, the available literature suggests that the prevalence of chronic wounds complicated with fungal infections ranges between 6% and 40%, across a variety of chronic wounds such as diabetic foot ulcers, nonhealing surgical wounds, and pressure ulcers.1 While the majority of fungi are harmless, certain species can cause serious infections.23

The fungal species tested in the current study can cause a variety of diseases, including life-threatening systemic infections (Table 2).24-34 Candida species are the most common fungi found in chronic wounds.35 In particular, C auris is resistant to multiple antifungal drugs used to treat Candida species infections.26 Remarkably, in the current study SOS was able to kill 99.9999% of C auris in 1 minute. C auris has been found to exhibit resistance to fluconazole and variable susceptibility to other azoles, amphotericin B, and echinocandins, and is associated with mortality rates as high as 72%.36,37 Alarmingly, clonal inter- and intra-hospital transmission of this difficult-to-treat yeast has become widespread in several countries, causing a broad range of health care-associated invasive infections in a short period of time.38
Most fungal and bacterial infections can be treated with drugs. However, for drug-resistant fungi and bacteria, their genes evolve so quickly that the treatment becomes ineffective and allows the dangerous disease to spread.39 Use of SOS for wound infection prevention and control may reduce the need to perform confirmatory diagnostic procedures when faced with a suspected fungal infection and subsequently decrease the burden on laboratories, the time from infection onset to treatment, and the use of inappropriate antifungal therapies.
The findings of the current study suggest that SOS displays broad-spectrum fungicidal activity against C albicans, C auris, C tropicalis, C parapsilosis, S schenckii, and T mentagrophytes. These results are likely to be related to the presence of HOCl (0.003%) in SOS. Accordingly, previous research findings have suggested that HOCl is the main antimicrobial component of SOS.17,21,40 In 1981, Albrich et al41 reported that antimicrobial activity of HOCl was possibly contributed by its ability to oxidize nucleotides, activate latent enzymes, or even inactivate enzymes and electron transport systems, thereby disrupting basement membranes or cell membranes of pathogens. HOCl is a nonselective oxidant that reacts with biomolecules, including nucleotides and enzymes, to exert its antimicrobial effects.13,14
Limitations
This study has several limitations. Only 6 fungal species were tested, so it is unclear whether SOS would display the same fungicidal activity for all fungi. Nevertheless, SOS displayed substantial fungicidal activity against Candida species, the most common fungal agent in wound infections.35 Additionally, the effectiveness of SOS was not compared with that of commonly administered antifungals. SOS should be tested in humans, and compared with antifungal medications, to confirm whether the in vitro results of this study can be translated to the clinical setting. Although the results of this preliminary in vitro study are promising, fungi were cultured on agar plates which do not effectively mimic the physiological conditions in chronic wounds. As a result, potential fungal defenses that may have been activated in a chronic wound setting may not have been available in vitro. In addition, the SOS used in this study is one of multiple commercially available SOS products.
Conclusions
The potent in vitro fungicidal activity shown by SOS against the selected fungi suggests that SOS may be an effective tool to treat and prevent fungal infections in hospital- and health care-associated settings. Furthermore, SOS may be an ideal choice for wound irrigation and debridement owing to its antimicrobial effects, which help to prevent wound infections and accelerate the wound healing process. These preliminary in vitro results warrant further investigation to determine whether the fungicidal activity of SOS is maintained in humans. Future studies could compare the effectiveness of SOS with that of topical antifungals to investigate whether SOS has enhanced activity against biofilms. Alternatively, future clinical studies could compare the effectiveness of SOS and conventional antiseptics on chronic wound infections and monitor wound healing progression in these patients.
Acknowledgments
Authors: Ranjeni Krishnen, PhD1; and Sreedharan Muniandy, MBBS2
Affiliations: 1Bactiguard (South East Asia), Simpang Ampat, Penang, Malaysia; 2Woundcare Unit, H Ambulatory Care Centre, Bayan Lepas, Penang, Malaysia
ORCID: Krishnen, 0000-0003-0634-7219
Disclosure: Bactiguard AB provided financial support for the study. Medical writing support was provided by Meridian HealthComms Ltd (Plumley, UK), funded by Bactiguard AB. R.K. is an employee of Bactiguard AB. S.M. discloses no financial or other conflicts of interest.
Correspondence: Ranjeni Krishnen, PhD;
308b, Jalan Perindustrian Bukit Minyak 18,
Penang Science Park, 14100 Penang, Malaysia; Ranjeni.Krishnen@bactiguard.com
References
1. Ge Y, Wang Q. Current research on fungi in chronic wounds. Front Mol Biosci. 2022;9:1057766. doi:10.3389/fmolb.2022.1057766
2. Guo S, Dipietro LA. Factors affecting wound healing. J Dent Res. 2010;89(3):219-229. doi:10.1177/0022034509359125
3. Frykberg RG, Banks J. Challenges in the treatment of chronic wounds. Adv Wound Care (New Rochelle). 2015;4(9):560-582. doi:10.1089/wound.2015.0635
4. Sinha M. Advance measures and challenges of wound healing. J Pharmacol Ther Res. 2018;2(1):1-3. doi:10.35841/pharmacology.2.1.1-3
5. Murphy EC, Friedman AJ. Use of in-office preparations by dermatologists for the diagnosis of cutaneous fungal infections. J Drugs Dermatol. 2019;18(8):798-802.
6. Wilson AP, Gibbons C, Reeves BC, et al. Surgical wound infection as a performance indicator: agreement of common definitions of wound infection in 4773 patients. BMJ. 2004;329(7468):720. doi:10.1136/bmj.38232.646227.DE
7. Kozel TR, Wickes B. Fungal diagnostics. Cold Spring Harb Perspect Med. 2014;4(4):a019299. doi:10.1101/cshperspect.a019299
8. Yeroushalmi S, Shirazi JY, Friedman A. New developments in bacterial, viral, and fungal cutaneous infections. Curr Dermatol Rep. 2020;9(2):152-165. doi:10.1007/s13671-020-00295-1
9. Gupta AK, Renaud HJ, Quinlan EM, Shear NH, Piguet V. The growing problem of antifungal resistance in onychomycosis and other superficial mycoses. Am J Clin Dermatol. 2021;22(2):149-157. doi:10.1007/s40257-020-00580-6
10. Gupta AK, Venkataraman M, Renaud HJ, Summerbell R, Shear NH, Piguet V. The increasing problem of treatment-resistant fungal infections: a call for antifungal stewardship programs. Int J Dermatol. 2021;60(12):e474-e479. doi:10.1111/ijd.15495
11. Eftekharizadeh F, Dehnavieh R, Noori Hekmat S, Mehrolhassani MH. Health technology assessment on super oxidized water for treatment of chronic wounds. Med J Islam Repub Iran. 2016;30:384.
12. Haesler E. WHAM evidence summary: super-oxidised solutions for chronic wounds. WPR. 2020;28(3):145-147. doi:10.33235/wpr.28.3.145-147
13. McKenna SM, Davies KJ. The inhibition of bacterial growth by hypochlorous acid. Possible role in the bactericidal activity of phagocytes. Biochem J. 1988;254(3):685-692. doi:10.1042/bj2540685
14. Gray MJ, Wholey WY, Jakob U. Bacterial responses to reactive chlorine species. Annu Rev Microbiol. 2013;67:141-160. doi:10.1146/annurev-micro-102912-142520
15. Martínez-De Jesús FR, Ramos-De la Medina A, Remes-Troche JM, et al. Efficacy and safety of neutral pH superoxidised solution in severe diabetic foot infections. Int Wound J. 2007;4(4):353-362. doi:10.1111/j.1742-481X.2007.00363.x
16. Del Rosso JQ, Bhatia N. Status report on topical hypochlorous acid: clinical relevance of specific formulations, potential modes of action, and study outcomes. J Clin Aesthet Dermatol. 2018;11(11):36-39.
17. Sakarya S, Gunay N, Karakulak M, Ozturk B, Ertugrul B. Hypochlorous acid: an ideal wound care agent with powerful microbicidal, antibiofilm, and wound healing potency. Wounds. 2014;26(12):342-350.
18. Kapur V, Marwaha AK. Evaluation of effect and comparison of superoxidised solution (oxum) v/s povidone iodine (betadine). Indian J Surg. 2011;73(1):48-53. doi:10.1007/s12262-010-0189-y
19. Aragón-Sánchez J, Lázaro-Martínez JL, Quintana-Marrero Y, Sanz-Corbalán I, Hernández-Herrero MJ, Cabrera-Galván JJ. Super-oxidized solution (Dermacyn Wound Care) as adjuvant treatment in the postoperative management of complicated diabetic foot osteomyelitis: preliminary experience in a specialized department. Int J Low Extrem Wounds. 2013;12(2):130-137. doi:10.1177/1534734613476710
20. Gunaydin M, Esen S, Karadag A, et al. In vitro antimicrobial activity of Medilox® super-oxidized water. Ann Clin Microbiol Antimicrob. 2014;13:29. doi:10.1186/1476-0711-13-29
21. Wang L, Bassiri M, Najafi R, et al. Hypochlorous acid as a potential wound care agent: part I. Stabilized hypochlorous acid: a component of the inorganic armamentarium of innate immunity. J Burns Wounds. 2007;6:e5.
22. Armstrong DG, Bohn G, Glat P, et al. Expert recommendations for the use of hypochlorous solution: science and clinical application. Ostomy Wound Manage. 2015;61(5):S2-S19.
23. Strickland AB, Shi M. Mechanisms of fungal dissemination. Cell Mol Life Sci. 2021;78(7):3219-3238. doi:10.1007/s00018-020-03736-z
24. de Lima Barros MB, de Almeida Paes R, Schubach AO. Sporothrix schenckii and Sporotrichosis. Clin Microbiol Rev. 2011;24(4):633-654. doi:10.1128/cmr.00007-11
25. Sanglard D, Odds FC. Resistance of Candida species to antifungal agents: molecular mechanisms and clinical consequences. Lancet Infect Dis. 2002;2(2):73-85. doi:10.1016/s1473-3099(02)00181-0
26. Whaley SG, Berkow EL, Rybak JM, Nishimoto AT, Barker KS, Rogers PD. Azole antifungal resistance in Candida albicans and emerging non-albicans Candida species. Front Microbiol. 2016;7:2173. doi:10.3389/fmicb.2016.02173
27. Emara M, Ahmad S, Khan Z, et al. Candida auris candidemia in Kuwait, 2014. Emerg Infect Dis. 2015;21(6):1091-1092. doi:10.3201/eid2106.150270
28. Jeffery-Smith A, Taori SK, Schelenz S, et al. Candida auris: a review of the literature. Clin Microbiol Rev. 2017;31(1): e00029-17. doi:10.1128/cmr.00029-17
29. Lee WG, Shin JH, Uh Y, et al. First three reported cases of nosocomial fungemia caused by Candida auris. J Clin Microbiol. 2011;49(9):3139-3142. doi:10.1128/jcm.00319-11
30. Behzadi P, Behzadi E, Ranjbar R. Urinary tract infections and Candida albicans. Cent European J Urol. 2015;68(1):96-101. doi:10.5173/ceju.2015.01.474
31. Trofa D, Gácser A, Nosanchuk JD. Candida parapsilosis, an emerging fungal pathogen. Clin Microbiol Rev. 2008;21(4):606-25. doi:10.1128/CMR.00013-08
32. Lima R, Ribeiro FC, Colombo AL, de Almeida JNJ. The emerging threat antifungal-resistant Candida tropicalis in humans, animals, and environment. Front Fungal Biol. 2022;3:957021. doi:10.3389/ffunb.2022.957021
33. Kaufman G, Horwitz BA, Duek L, Ullman Y, Berdicevsky I. Infection stages of the dermatophyte pathogen Trichophyton: microscopic characterization and proteolytic enzymes. Med Mycol. 2007;45(2):149-155. doi:10.1080/13693780601113618
34. Huppler AR, Bishu S, Gaffen SL. Mucocutaneous candidiasis: the IL-17 pathway and implications for targeted immunotherapy. Arthritis Res Ther. 2012;14(4):217. doi:10.1186/ar3893
35. Dowd SE, Delton Hanson J, Rees E, et al. Survey of fungi and yeast in polymicrobial infections in chronic wounds. J Wound Care. 2011;20(1):40-47. doi:10.12968/jowc.2011.20.1.40
36. Morales-López SE, Parra-Giraldo CM, Ceballos-Garzón A, et al. Invasive infections with multidrug-resistant yeast Candida auris, Colombia. Emerg Infect Dis. 2017;23(1):162-164. doi:10.3201/eid2301.161497
37. Lone SA, Ahmad A. Candida auris–the growing menace to global health. Mycoses. 2019;62(8):620-637. doi:10.1111/myc.12904
38. Chowdhary A, Sharma C, Meis JF. Candida auris: a rapidly emerging cause of hospital-acquired multidrug-resistant fungal infections globally. PLoS Pathog. 2017;13(5):e1006290. doi:10.1371/journal.ppat.1006290
39. Perlin DS, Rautemaa-Richardson R, Alastruey-Izquierdo A. The global problem of antifungal resistance: prevalence, mechanisms, and management. Lancet Infect Dis. 2017;17(12):e383-e392. doi:10.1016/s1473-3099(17)30316-x
40. Selkon JB, Babb JR, Morris R. Evaluation of the antimicrobial activity of a new super-oxidized water, Sterilox, for the disinfection of endoscopes. J Hosp Infect. 1999;41(1):59-70. doi:10.1016/s0195-6701(99)90038-5
41. Albrich JM, McCarthy CA, Hurst JK. Biological reactivity of hypochlorous acid: implications for microbicidal mechanisms of leukocyte myeloperoxidase. Proc Natl Acad Sci U S A. 1981;78(1):210-214. doi:10.1073/pnas.78.1.210


